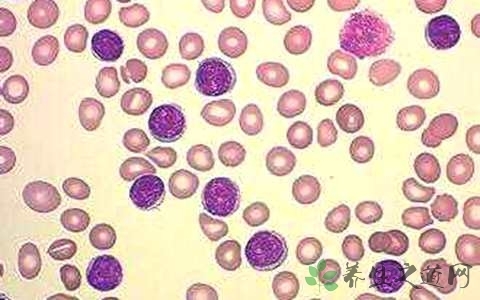
老年人白细胞高是什么原因

我家小孩白细胞高,是什么原因?
320x240 - 11KB - JPEG

检查尿的白细胞数值是150,是不是高
650x389 - 41KB - JPEG

三十五周5坐的尿常规,红细胞和白细胞都高,而
828x1104 - 394KB - JPEG

白细胞数940,是什么情况
400x400 - 19KB - JPEG

【白血球过高】_白血球高_怎么回事_为什么_
500x370 - 51KB - JPEG

白细胞17.4,发烧经常血象高是什么原因
600x364 - 58KB - JPEG

孩子2个月大 发烧2次 白细胞过高 真的需要住院
640x480 - 52KB - JPEG

26周+5去杭州妇保做尿常规检查,白细胞计数和
440x264 - 25KB - JPEG

白细胞高_宝宝十一个月了,精神很好 也没有什
640x480 - 48KB - JPEG

血糖结果白细胞指数过高!有懂的宝妈吗_医院快
640x640 - 58KB - JPEG

【尿里白细胞高应该怎么办?】
500x344 - 34KB - JPEG

一岁男宝,尿检白细胞超高,是什么问题?_专家在
390x526 - 40KB - JPEG

白细胞介素6高是什么原因
480x300 - 54KB - JPEG

白细胞介素6高是什么原因
480x300 - 46KB - JPEG
老年人白细胞高是什么原因
480x300 - 86KB - JPEG
您好,根据您的描述,不太明白白=血球比值的意思,您是想询问肝功能中的白球比或白血球数值的问题吗?如果是白球比一般用于检测是哪种类型的肝功能损伤,如果是后者通常是
问:白细胞数值175很高什么情况?(男,78岁)答:您好,您的问题已收到,正在分析病情,请稍等 用户端App 春雨医生App 扫描二维码 安装春雨医生App 医生端App 春雨诊所App 扫描
当身体产生了炎症,或者有身体的过激反应,就会导致白细胞偏高,一般白细胞偏高,应该在医生的指导下积极做抗炎治疗。如果你还有什么疑问,可以继续问我。如果觉得我的回答满意,希望采纳。
1)白细胞数值:成年人外周血液中正常的白细胞数值是4~10×109/L,如果少于4×109/L为白细胞减少,超过10×109/L及为白细胞增多。 (2)白细胞分类计数:在外周血液中可以看到的白细胞,一般可分:中性粒细胞,嗜酸性粒细胞,嗜碱性粒细胞,淋巴细胞,单核细胞等五种;其中以中性粒细胞最多,其次为淋巴细胞,其他的白细胞很少。所谓白细胞分类计数就是计算各种白细胞在它的总数中所占的百分比数 。正常值为:中性粒细胞:50~70%,嗜酸性粒细胞:0.5~5% ,嗜碱性粒细胞:0~1%, 淋巴细胞:20~40%,单核细胞1~8%。 (3)白细胞的数值,除了疾病因素可以引起变化外,亦受生理因素及其他原因影响,餐后、剧烈运动、寒冷、疼痛、恐惧等可致白细胞升高;冬天白细胞比夏天高,下午检查比清晨高;妊娠亦可使白细胞升高。白细胞依细胞质内有无颗粒,分为粒细胞与无粒细胞两大类。粒细胞依其颗粒染色特征不同又分为中性粒细胞、嗜酸性粒细胞和嗜碱性粒细胞。无粒细胞又分为单核细胞和淋巴细胞。淋巴细胞依其功能又分为若干种。成年人白细胞数为每立方毫米5000~9000 ,其中中性粒细胞占0.50~0.70,嗜酸性粒
幼儿急疹属于病毒感染导致的,一般情况白细胞数正常或者偏低。单纯幼儿急疹很少白细胞数偏高的,但也有的宝宝因为化验血时哭闹严重导致白细胞数量升高的。
简介:白细胞(英文名:leukocyte,white blood cell,简称:WBC),旧称白血球。血液中的一类细胞。白细胞分为中性粒
可能是有过敏的情况,建议手工复查血涂片,在进行治疗。
指导意见:你宝宝7个多月,发烧后咳嗽,白细胞降到1.3万,还偏高, 因为呼吸道炎症引起,最好去医院拍片确诊,或让医生听诊的,必要时可以口服头孢克洛或阿莫西林克
病情分析: 你好,白细泡高,就是感染的情况,建议口服消炎药物治疗,看看 消炎药物有,阿莫西林,环丙沙星,可以一起口服使用的,
状况了。那么,引起白细胞高的因素有哪些?假如你的白细胞高在饮食上应该注意什么?让 当我们口服或者输液一些药物时,白细胞的数值也一定会受